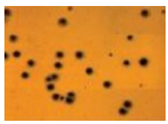
Coatings 09 00173 i005

Abstract
Achieving special features in polymer composites, such as flame retardancy and thermal and electrical conductivity, often requires the application of different additives, which might negatively affect other properties of the polymer matrix and the composite structure. Furthermore, the application of solid additives in composites produced by liquid transfer moulding can lead to the filtration of the additive by the reinforcement, which causes a non-uniform particle distribution and an uneven performance. An evident solution to address these issues is to apply the additives in a separate layer on the surface of the composite. As in many applications, gelcoats are used to reach appropriate surface quality, a reasonable progression in the composite industry is the development of multifunctional gelcoats. In this article, after a short introduction to gelcoats and their main base materials (unsaturated polyester, epoxy, and others) multifunctional gelcoats are discussed according to their functionality, in particular water resistance, electric conductivity and flame retardancy. Classical and novel gelcoat preparation methods (application by brush and/or roller, spraying, UV-curing, in-mould gelcoating), as well as common defects that occur during gelcoating are discussed. Finally, the testing methods of multifunctional gelcoats are outlined.
1. Introduction
Liquid transfer moulding techniques, such as resin transfer moulding (RTM) get more and more attention in the composite industry due to their significant advantages over traditional techniques, such as hand lamination: high productivity at lower cost, increased fiber-to-resin ratio, controlled dimensional tolerances, providing outstanding reproducibility. Therefore, these techniques are common in the production of automotive and aircraft structural elements [1,2], which often require special features, such as flame retardancy and thermal and electrical conductivity. These properties are usually achieved with the application of different additives, which might adversely influence other properties of the polymer matrix and the composite structure, such as crosslinking density, glass transition temperature and mechanical behavior. During liquid transfer moulding processes, a liquid resin is injected into a preform consisting of fiber reinforcement and then cured, therefore the phase of the additive and its effect on the viscosity of the matrix plays an important role. If the applied additive is solid-phased, it can be filtered by the reinforcement during the injection phase, which causes a non-uniform particle distribution and an uneven performance [3]. To avoid this phenomenon, liquid-phase additives can be applied, as they can be more easily integrated into the RTM process. In the case of flame retardants, besides particle filtration, the fiber reinforcement layers also interfere in the solid phase action of the flame retardants by hindering the formation of an intumescent char on the surface of the composite [4]. Furthermore, even this hindered charring is sufficient to delaminate the composite layers, leading to a catastrophic loss of the post-fire mechanical properties. In the case of hand lamination, no filtration of the solid particles occurs, as the reinforcement layers are impregnated one by one, furthermore it is less sensitive to increased viscosities, but it is less productive and the achievable maximum fiber content is lower, therefore liquid transfer moulding techniques are preferred in many industries.
An obvious solution to overcome all these issues related to the application of additives in composites produced by liquid transfer moulding is to apply the necessary additives in a separate layer on the surface of the composite, although this would include an additional processing step. As in many application areas, gelcoats are used anyway to reach the required surface properties, a logical progression in the composite industry is the development of multifunctional gelcoats. In this article, after a short introduction to gelcoats and their base materials, multifunctional gelcoats are discussed according to their functionality.
2. Gelcoats and Multifunctional Gelcoats
According to Borsting et al., a gelcoat is a material used to provide a high-quality finish on the visible surface of the finished composite part [5]. Gelcoats are resin systems dissolved usually in styrene or other organic solvents; the polymerization reaction takes place on the surface of the product. The main function of these gelcoats is surface protection, aesthetic appearance but other functionalities can be available with additives. Gelcoats and topcoats must be distinguished. During the production method of the composite, gelcoats are sprayed or brushed on the surface of the mould surface in liquid state before the lamination process (Figure 1 based on [6]). In contrast, top coats are applied on the direct surface of the cured composite part. Top coats do not need a separate curing process, as the crosslinking takes place under atmospheric conditions.

Figure 1.
Scheme of the hand lamination process.
Although gelcoats and topcoats have to be distinguished, their composition is similar. Standard gelcoats and topcoats are responsible for surface protection and aesthetic appearance. These standard systems are neat resins (unsaturated polyester resins, epoxy resins, vinyl ester resins etc.) in an organic solution form. Usually, the applied gelcoat and the matrix of the composite are the same type of resin, to achieve a strong bond between the molecules, and thereby produce a durable gelcoat. Besides the neat resins, gelcoat systems often contain reactive diluents (to adjust the viscosity of the gelcoat), and additives or fillers as well (to enhance existing or provide new properties).
2.1. Unsaturated Polyester, Epoxy, and Epoxy-Compatible Unsaturated Polyester Gelcoats
The most common gelcoat systems used are unsaturated polyester (UP) gelcoats, and epoxy (EP) gelcoats, but sometimes other materials are applied as well (such as EP-compatible UP gelcoats, vinyl ester gelcoats etc.), especially when special properties are required. The most common gelcoat systems are listed below.
2.1.1. Unsaturated Polyesters
Unsaturated polyester (UP) resins are primarily linear polycondensation products usually made from unsaturated acids and polyvalent alcohols, solved in a reactive styrene monomer. The key building block of UP resins is maleic anhydride which is reacted with ethylene glycol to form unsaturated polyester chains. Some of the maleic anhydride molecules are rearranged to form fumaric acid ester, which is a more reactive compound. For the crosslinking process of UP resins, heat and/or the presence of catalysts and accelerators are required. The most common compounds applied are vinyl monomers, which serve as solvent for the polyester and reduce its viscosity, at the same time they act as copolymerization agent during the curing process [7]. The unsaturated polyester chains are usually linked together with styrene monomers [8] by radical polymerization, which is the most cost-effective method that yields highly crosslinked thermosets, however other compounds such as acrylates, methacrylates, cyanurates, maleic acid esters, diallyl phthalate, and different vinyl esters and ethers can be used as well [7,8]. For example, special formulations containing triethylene glycol divinyl ether instead of styrene are suitable for UP gelcoats [9]. These compounds have a different reactivity towards UP resins in comparison to styrene; some of them only react with UP resins at high temperatures [8]. UP resins are transparent systems with a low viscosity and good chemical resistance at an affordable price level, but their mechanical properties are usually weaker in comparison to epoxy resins. Applying UP resins at high temperatures is not recommended because they easily decompose by oxidation, while at low temperatures their rigidity limits the possibilities of application. UP resins are available as monomers, reactive thinners but most importantly as reactive solvents. Despite the reduction of the maximum threshold limit values for styrene (the maximum allowable workplace concentrations and threshold limit values vary widely from country to country), it is still the main copolymerization partner for unsaturated polyester resins. Ambient temperature processes (e.g., resin transfer moulding (RTM), vacuum-assisted resin transfer moulding (VARTM)) often require a redox initiator system for radical polymerization. Basically, three ways are available to initiate the polymerization reaction of UP oligomers [8]:
- hydroperoxide initiator with a heavy metal salt promotor (usually cobalt);
- acyl peroxide initiator with an amine type promotor (usually tertiary aromatic amine);
- photoinitiator with UV radiation.
Commonly used initiator systems contain cobalt (Co) salts of carboxylic acids (such as Co-octoate or Co-naphthenate) as promotor, which is responsible for the decomposition of the peroxide type initiator. The decomposition of the peroxide induces free radical polymerization, which yields increasing resin temperature because of the exotherm reaction [10,11]. The temperature rise also accelerates the curing reaction of the UP resin [12]. However, a fully cured polymer (~100% conversion) is hard to achieve, when process takes place at room temperature, therefore a post-curing step is often needed. At room temperature, a high level of peroxide should be used to obtain UP resin with low styrene residue [13], although a high initiator concentration may result in low molecular weight and insufficient mechanical properties of the cured resin or composite. Some effort has been made recently to improve initiator systems for better performance at low temperature cure [14,15]. High temperature curing systems usually contain two or more peroxides, where the low temperature peroxide rapidly initiate the polymerization, while the high temperature peroxide decomposes slowly first, then becomes highly active due to the exotherm heat effect of the reaction [16]. This concept can be suitable for low temperature manufacturing processes as well. For example, Li et al. investigated a combined peroxide initiator system containing methyl ethyl ketone peroxide (MEKP) as a low temperature peroxide and tert-butyl peroxybenzoate (TBPB) as high temperature peroxide with cobalt octoate as promotor [17]. Researchers found that the combination of these peroxides showed a synergistic effect on the curing reaction of UP resin in comparison to single initiator systems: shortened the processing time, increased final conversion of the resin, while provided long enough pot life and gel time, which is favorable for processing [17].
The first usable and still one of the most important methods to form a tack-free surface was the addition of paraffin wax to the UP resin. Relatively small amounts are required: approx. 0.1% or less from hard paraffin wax or 1% to 2% in the case of stearins. The paraffin (wax or stearin) is soluble in the UP resin coating but its solubility decreases when the crosslinking process of the UP resin begins. During the crosslinking reaction, paraffin migrates to the surface of the paint film to form an impermeable layer, which not only acts as a barrier to atmospheric oxygen but also reduces the evaporation of monomeric styrene [8]. In order to prevent the crystallization reaction of the paraffin wax before application, it is usual to add the wax solution with the co-accelerator solution shortly before application. After the gelation of the coating at room temperature, it can be force-cured at elevated temperatures [8]. A suitable alternative to the addition of paraffin wax is to modify the polymer chain by incorporating autooxidating groups (e.g., allyl or benzyl ethers of polyvalent alcohols, usually mono- or diallyl ethers of glycerols and mono-, di-, and triallyl ethers of pentaerythritol). These modified resins are known as air-drying or wax-free polyesters [8]. However, it should be mentioned that in order to obtain high-gloss surfaces, the applied paint film must be sanded and polished.
2.1.2. Epoxy Resins
Epoxy resins (EP) are crosslinked polyaddition products made from compounds containing at least one oxirane group per molecule (epoxy compound) and curing agent (usually amine or anhydride compound) [8]. It is important that the reactivity and functionality of the epoxy compound and the curing agent (crosslinking compound) must correspond to each other. A wide range of epoxy resins can be synthesized depending on the number of functional groups. Diepoxide compounds with bifunctional addition components result in linear, soluble structures, while adding a small amount of tri- or tetrafunctional components leads to branched soluble structures. Because of the numerous possibilities of combining resins and curing agents, the properties of epoxy resin systems are particularly easy to adjust (viscosity, rheological characteristics and properties of the end product). The properties can be tailored further with the incorporation of additives (fillers, reinforcements, flame retardants, pigments etc.).
EP resins can be synthesized via direct or indirect methods. In the case of direct methods, mainly per-acids, hydrogen peroxide or oxygen are used. The industrial importance of these chemical routes is unquestionable, as these methods produce halogen-free epoxy resins. Considering the indirect methods, the addition of active hydrogen atoms is the key. The preparatively or technically advantageous ways are the following: the addition of compounds with active hydrogen atoms to chlorohydrins (e.g., epichlorohydrin), or to di-, tri- or poly-epoxide compounds by the reaction of only one epoxide group per molecule. The synthesis via epichlorohydrin has high industrial importance. The purity of the formed products depends on the molar ratio of the compounds and on the reaction conditions [8]. Bisphenol A diglycidylether (DGEBA) is not only historically but industrially important as it comprises more than 85% of the volume of epoxy resin production. In industrial production, advanced epoxy resins are synthesized, preferably with bisphenols (e.g., DGEBA) for targeted adjustment of the average molecular mass. The reaction of DGEBA with epichlorohydrin or phenols results in an industrially usable epoxy gelcoat system with tailored molecular mass and properties [8]. Dicarboxylic acids and aromatic amines can be used with di-, tri-, and tetra-glycidyl compounds to produce fusible and soluble preadducts which still have free terminal epoxide groups. This chain extension and structure variation process is exploited commercially; the preadducts are reacted and crosslinked with curing agents by the user. These systems require detailed investigation, because reproducibility strongly depends on reaction parameters. Industrially important epoxide compounds are the following [8]:
- Bisphenol F epoxy resins and phenol-novolac glycidylether
- Cresol-novolac glycidylether
- Cycloaliphatic glycidyl compounds (weather resistance)
- Epoxidized cycloolefins (cycloaliphatic epoxy resins; weather resistance)
- Glycidyl compounds containing bromine
- N-glycidyl compounds of hereocycles and amines
- Aliphatic glycidylethers (reactive diluents)
- Cycloaliphatic and aromatic glycidylethers, glycidylesters (reactive diluents)
In order to prepare highly crosslinked epoxy resins, a curing agent is required. A curing reaction can be a homopolymerization initiated by a catalytic hardener or a polyaddition or copolymerization reaction with a multifunctional crosslinker [18]. Curing agents for epoxy resins are usually nitrogen-, oxygen- or sulphur-containing organic compounds with different reactivity to epoxy compounds, therefore users should choose according to manufacturing process and application. Aliphatic, cycloaliphatic and aromatic amines and their derivatives are often used in the industry because of the relatively fast reaction and their effectiveness. Aliphatic amines react fast even at ambient temperatures, while cycloaliphatic and aromatic amines react only slowly with epoxy compounds at low temperatures [18,19]. Carboxylic acids and anhydrides are the second most important family of curing agents for epoxy resins, however they are only practical in the case of high-temperature manufacturing (e.g., carboxylic acids in heat-cured surface coatings) [18]. Thiol or mercaptan group can also react with epoxy group, although the reaction requires catalysis at room temperature, usually by amines, which promote the production of reactive mercaptide ions [18,19]. Besides the low moisture resistance of the mercaptan-cured epoxy resins, the unpleasant odour of mercaptans limits their application in the industry including surface coatings [8,18,19].
It is obvious, that a huge number of epoxy compound and curing agent combinations are available in the case of epoxy resins. With the adequate combination, properties can be tailor-made by users. Epoxy gelcoat systems have a technical and commercial importance in the field of surface protection. Because of the almost unlimited possibilities of combinations of resin and curing agent, they can satisfy wide demand profiles in different areas of application (Table 1).

Table 1.
Epoxy gelcoat systems and their typical application.
In the case of epoxy resin applications, some aspects should be taken into account. Non-modified liquid resins based on bisphenol A have no significant irritation of skin or mucous membranes, but they can act as sensitizers and cause dermatological allergies. Solid epoxy resins based on bisphenol A are non-toxic materials and so are novolac-epoxy resins. Reactive thinners usually have low viscosity, low molecular mass and noticeable vapor pressure, so they must be handled with care [8,20]. Nevertheless, their main disadvantage is flammability, which plays a key role in engineering applications for example in the automotive and aerospace industry.
2.1.3. Other Gelcoat Resin Systems
Although UP and EP resins are the most commonly used polymer resin materials for coatings, there are some other special resins used in the industry, e.g., silicone resins, more precisely polyorganosiloxanes. These compounds are directly bonded to carbon, and they can have at least one bond to oxygen as well. Because of these bonds, silicone resins have an inorganic and an organic character as well: the siloxane link is responsible for the inorganic properties, while the organic properties arise from the bonding of silicon with carbon atoms. Most of these products are thermally stable (over the range of −50 to 200 °C), have good weather and ozone resistance, and good dielectric, and water repellent properties [8]. Their main application areas are electrical engineering and the building industry. To name just a few other possible coating systems applied in different industrial fields: amino resins, phenolic resins, ketone and aldehyde resins, polyisocyanate resins, water-glass and alkyl silicates, rubber-based resins and related polymers, cellulose derivatives, and also different inorganic compounds [8]. As there are many different materials and combinations, it only depends on the user and the application which type of resin is chosen. However, one thing is very important before application. A gelcoat provides mechanical protection on the surface. To function well, the gelcoat resin compound needs excellent adhesion to the composite matrix. Without this, the gelcoat loses its main function, and the composite structure becomes vulnerable.
2.2. Multifunctional Gelcoats
As mentioned above, the primary function of gelcoats is mechanical protection and aesthetic appearance of the surface. However, there are some applications where special functions are needed. These special requirements usually cannot be provided by basic gelcoat systems, but the properties of the gelcoat can be tailored with additives. Coating additives are substances, added in small quantities to coating formulations, to improve certain properties during manufacturing, storage or application [8]. Apart from the main components, such as binders, pigments and solvents, additives determine properties to a large extent. The main additives are wetting and dispersing agents, thickening agents, coalescing agents, slip agents, driers, defoamers, but there are other additives for special requirements as well, such as UV stabilizers, antistatic additives, flame retardants, biocides, and fungicides. The properties can be easily modified with the application of these additives, but some of the additives are multifunctional in themselves in the sense that they affect various different properties (e.g., wetting and dispersing agents also generally affect the adhesion to the substrate and improve flow characteristics of the paint). To achieve these special properties, another important issue is the amount of the additive in the coating. The maximum amount of additives in coating formulations does not usually exceed 5%, calculated on the total weight of the formulation [8], but of course, there could be exceptions. The chemical composition of the various additives differs enormously from one type to another [21,22]. Some additives have a simple chemical composition (like silicones), others are preparations made from various components, or are natural compounds (e.g., lecithin), or modified natural products (for example cellulose derivatives). The importance of polymeric additives is increasing in the coating industry. These additives are mainly dispersing agents, thickeners or slip and mar resistance agents. Polymeric additives have superior efficiency, good film forming properties (comparable to binders) and improved mechanical and resistance properties [8]. Some of the multifunctional gelcoat systems are summarized below, according to their functionality.
2.2.1. Water Resistance
Gelcoats are widely used in the sailing industry. The outer surface of the hull is always covered with a gelcoat to save the composite structure. A gelcoat itself can provide some water resistance without any additives, although it is only temporary protection. Nowadays, natural fiber reinforced composites attract an increasing amount of interest because of the concept of sustainable development. Their huge disadvantage is the moisture sensitivity of the natural fibers. Because of the moisture, interfacial adhesion between the natural fibers and the matrix resin can decrease, causing a decrease in the load-bearing capacity of the composite structure. This phenomenon was studied by Sudha et al. with jute reinforced epoxy composites [23]. The researchers investigated the effect of an epoxy gelcoat on moisture absorption and mechanical properties. Coated and uncoated samples were made and studied. They found that the moisture absorption capacity of uncoated specimens was higher than the moisture absorption of coated specimens. The coated specimen absorbed moisture up to 4 h, and later it reached saturation level, because the gelcoat prevented moisture uptake. They stated that the process of gel coating reduces delamination, fiber degradation and polymer wetting. According to the authors, the exposure of natural fiber reinforced composites to moisture results in a significant drop in mechanical properties due to the degradation of the fiber-matrix interface. As the time of immersion increases, the brittleness of the epoxy matrix increases with a decrease in load-bearing capacity. They stated that when the water content reaches saturation level, the bound water and the free water remains in the composite as a reservoir. This softens the fibers and weakens fiber-matrix interfacial adhesion resulting in a deterioration in mechanical properties, such as tensile and flexural modulus. A gelcoat layer without any additives prevents moisture uptake, while the mechanical properties of the composite stay unchanged [23].
Although the gelcoat prevents moisture uptake without any additives, there are attempts to improve this effect. Moreover, gelcoats made from unsaturated polyester and vinylester resins (these are usually applied on boats, surfboards etc., because of their good mechanical properties, aesthetic appearance, and low price) include ester and hydroxyl groups, which are moisture sensitive. According to researchers, some additives can prevent the moisture degradation of resins. For example, Firdosh et al. tried to protect these types of resin coatings with nano-reinforcement [24]. One and two percent of montmorillonite (MMT) was introduced into an unsaturated polyester system and a vinylester resin coating system. Vinylester took up less moisture in comparison to unsaturated polyester and the addition of the nanoparticles decreased moisture uptake, though a higher amount of MMT resulted in higher values. This phenomenon can be explained with the aggregation of nanoparticles at higher loadings; the aggregation of the particles results in uneven distribution and worse moisture resistance [24].
2.2.2. Electric Conductivity
Another great problem of polymer materials is their insufficient electrical conductivity. The aerospace industry applies strict safety regulations, among others related to the lightning protection of aircraft. Polymers have bad electrical conductivity because of their few free electrons, therefore the Faraday-cage principle is not applicable in their case. For this reason, in the event of a lightning strike, passengers may also be exposed to the harmful effects of fire, high voltage or electrical equipment malfunctions. Yardimci et al. investigated the electrical conductivity of an unsaturated thermoset polyester-based gelcoat system containing 0.05% of carbon nanotubes (CNTs) made by the methane decomposition catalytic chemical vapor deposition method [25]. They dispersed CNTs within the gelcoat using 3-roll milling, then examined the electrical properties of the samples in AC electric field. They found that the neat polymer resin had high resistance, while the addition of CNTs decreased increased conductivity. AIMPLAS, a Spanish plastics organization, developed a powder gelcoat with electrical conductivity properties by the incorporation of carbonaceous fillers [26]. The conventional use of coatings has some important limitations, such as volatile organic compounds (VOC) emission and long curing time. AIMPLAS achieved a significant reduction of curing time, from an hour to just a few minutes. This also reduces VOC emission during the polymerization reaction. Electrical conductivity, caused by carbonaceous fillers, allows eliminating secondary painting stages for the final finish with electrostatic paint. Because of this fact, manufacturing costs can be lower, while productivity rises. The researchers found that the coating is recyclable, and any excess applied on the mould can be recovered and reused. They stated that the application of this coating could give antistatic properties to products such as fuel tanks and pipes in the construction sector [26]. Henkel’s portfolio of aerospace surfacing films is focused on lightweight structures, enhanced surface quality, protection from lightning strikes, and improved manufacturing efficiency [27]. These easy-to-use coatings are lightweight, provide a smooth surface and include the latest technology that provides protection for composite structures from lightning strikes. Earlier, manufacturers used a two-step process for lightning strike protection where first an adhesive film was applied, then a copper or aluminum mesh was embedded in the adhesive layer (Figure 2). Henkel provides ready-to-use films in which the adhesive and the conductive mesh are already integrated. An example: Henkel’s LOCTITE EA 9845 surfacing films are epoxy-based composite coatings made with non-woven fabric for support and are designed to improve the surface quality and protection of composite parts. This system provides UV protection and chemical resistance to protect the surface of the composite [27]. LOCTITE EA 9845 LC Aero was designed to provide the required protection in the most compromised lightning strike zones of an airplane (e.g., the cockpit and the jet engine) [27].

Figure 2.
Structure of a lightning strike surfacing film.
2.2.3. Flame Retardancy
In order to meet the strict safety requirements of more demanding sectors such as transport, electrical and electronic industries, the flame retardant (FR) properties of polymers have to be enhanced. For this purpose, halogen-containing FRs are highly effective, however their corrosiveness and toxicity limits their use in many application areas. The increasing focus on health and environmental compatibility of FRs lead to a steady expansion of non-halogenated phosphorus, inorganic and nitrogen flame retardants, so called PIN FRs. Among these, the development of new phosphorus-containing FRs [28,29,30,31] is a widely researched area. Recently, different nanomaterials (such as montmorillonite [32,33,34], carbon nanotubes [35,36,37], and graphene [38,39,40,41]) are investigated as well as possible FR additives, often in synergistic combination with other FRs.
Concerning the application a FRs, three main approaches have been quite well accepted and commonly used [42]. The first common approach involves the mechanical incorporation of flame retardant (FR) additives into the bulk polymer matrix, which is usually a low-cost and fast-blending technique. However, usually high loadings of FR needed for efficiency, which could influence the mechanical properties of the materials [43,44]. This method is called additive flame retardancy. The second way to reduce flammability is to bind units chemically to the polymer matrix with FR segments containing functional groups. This so-called reactive flame retardancy usually results in higher efficiency and a better long-term durability, because the FR element becomes an integral part of the polymer chain [45]. Such incorporation could change the morphology and physical properties of the polymer as well. The third approach mostly involves surface modification. Fireproof coatings became one of the most convenient, economical, and efficient way to protect surfaces against fire. FR coatings can provide excellent flame retardancy, while at the same time preserving the bulk properties of the material (e.g., mechanical properties). Besides, they offer mechanical protection and aesthetic appearance like basic gelcoat systems [46,47,48]. The properties of ideal flame retardant coatings are non-flammability, low thermal conductivity, similar heat expansion coefficient to the composite substrate, strong interfacial adhesion between the coating resin and the laminate matrix resin, weather and wear resistance, low weight and cost-effectiveness [49]. Due to their organic backbone, most of the gelcoat materials (especially UP and EP resins) are highly flammable, similarly to the polymer matrix material of the composites, therefore a logical progress of this field is to integrate the flame retardant feature into the applied gelcoat system.
Clariant researchers recently developed intumescent gelcoats for glass fiber reinforced UP resin laminates for railway and construction/building applications [50]. They investigated non-FR and flame retarded, coated laminate substrates made from two type of UP resins (with 30% glass fiber content). Flame retardant gelcoat contained an ammonium polyphosphate (APP) based intumescent FR additive, while the flame retarded laminate was filled with alumina trihydroxide (ATH). Specimens were examined according to German, French, and British railway and construction industry standards. The results showed that the application of an intumescent gelcoat on the surface of the composite can be advantageous in the industrial applications mentioned above. The gelcoat showed high efficiency and low smoke density, while it is non-toxic, and has no corrosive smoke. These advantages originate from the intumescent APP based FR additive in the gelcoat. Furthermore, no or less FR filler in the laminate substrate results in easier injection, because no significant increase in viscosity occurs. Also, higher fiber-to-resin ratios are possible, which can result in better mechanical properties [50].
There are a few commercially available FR gelcoat systems, but their exact composition is treated as an industrial secret by producers and distributors. Table 2 summarizes some of the commercially available FR gelcoat systems and their application.

Table 2.
Commercially available flame retardant gelcoat systems and their application.
In the case of liquid transfer moulded FR composites, the applied solid FRs can be filtered by reinforcement layers. This results in a non-uniform distribution of the particles and an uneven fire performance. Furthermore, fiber reinforcement often hinders the action of flame retardants acting in the solid phase. Also, the occurring char formation in the matrix leads to the delamination of the reinforcement layers, leading to the loss of post-fire mechanical properties. A possible solution to overcome these issues [58] is the application of a FR coating on the surface of the composite. Toldy et al. developed flame retarded carbon fiber reinforced epoxy composites with an intumescent epoxy resin coating layer [4]. Their coating consisted of an aliphatic, pentaerythritol-based epoxy resin and a phosphorus-containing amine which acted both as hardener and flame retardant. Two kinds of coated systems were developed with the same substrate; one of them had a 2 mm thick, the other had two 1 mm thick aliphatic intumescent coatings (one above and one below the composite substrate). In the case of the composite with 2 mm intumescent layer, the heat release rate (HRR) fluctuated around zero, while there was no ignition at all at a heat flux of 50 kW/m2. Researchers stated that in the coated composite, the solid-phase mechanism was not hindered and the carbon fiber reinforcement led away the accumulated heat from the char layer that formed and distributed it in the core [4]. Although the surface properties of this system were not tested, the total absence of ignition implies a promising future application of such reactive intumescent systems as FR gelcoats in the industry.
There are some commercially available intumescent and non-intumescent polymer coatings, which are effective only if they are applied in high thickness and high FR loadings, but this entails an increase in the weight of the composite part [59]. One possible route to reduce coating thickness and weight is the direct polymerization of FR monomers on the surface. Flame retardants containing phosphorus (P) are promising in this field. Phosphonate functional groups in the monomer allow the formation of a dense intumescent char layer on the surface, which protects the composite part [60]. These phosphorylated polymers can be prepared from compounds containing phosphonate functional groups (e.g., vinyl phosphonic acid (Figure 3), dialkyl vinyl phosphonates, and vinyl and allyl phosphine oxides) via copolymerization [61,62], or in the case of oligomeric compounds, via grafting [63,64].

Figure 3.
The structure of vinyl phosphonic acid (VPA).
Luangtriratana et al. developed a vinyl phosphonic acid (VPA) based coating with a flame retardant effect. The coating was painted on the surface of glass fiber reinforced epoxy composites with a thickness of 300 and 500 µm, then these coatings were cured by UV light [59]. According to morphological experiments (scanning electron microscopy (SEM), infrared spectroscopy-attenuated total reflection (IR-ATR)), a poly(vinyl phosphonic acid) (PVPA, Figure 4) layer was formed on the surface of the composites as a result of the UV light. However, because of the manufacturing technique (painting with a brush), the thicknesses of the coatings deviated slightly from the expected values. The PVPA layer seemed to be homogenic and fully covered the surface (Figure 5). The fire performance of the samples was investigated in a cone calorimeter with 35 and 50 kW/m2 heat fluxes. The coated samples did not ignite under 35 kW/m2. At 50 kW/m2, some specimens ignited, but there was a significant reduction in peak heat release rate (pHRR) and total heat release (THR) compared to the non-FR reference composite. Researchers found that the high efficiency of PVPA lies in its intumescent effect. They also stated that with increasing coating thickness, the thermal barrier effect increases as well. The best results were obtained with a thickness of ~500 µm [59]. Although the surface properties of this system were not reported, the direct polymerization of FR monomers on the surface is a promising concept, which could be used in the future to develop FR gelcoats effective even at small layer thickness.

Figure 4.
The structure of poly(vinyl phosphonic acid) (PVPA).

Figure 5.
SEM images of glass fiber reinforced epoxy composites with 0.3 (GRE-0.3PVPA) and 0.5 mm (GRE-0.5PVPA) thick PVPA coatings. Reprinted with permission from [59]; Copyright 2014 University of Bolton.
Although in the case of the FR surface coatings developed by Toldy et al. [4] and Luangtriratana et al. [59] were not tested as gelcoats, they show a promising future application of such systems as flame retardant gelcoats in the industry.
3. Gelcoating Techniques and Common Defects
In this section, most common gelcoat preparation techniques (classical and novel methods) and common defects are listed.
3.1. Classical Methods
There exist two classical gelcoating methods: application by brush and/or roller, and spraying. Using a brush is the easiest way to apply gelcoats. This method has the advantage of good air release and low emission of styrene, but the gelcoat should be colored to hide the brush strokes. Sometimes, two layers are applied with a thickness of approx. 300 µm. The second layer is applied after the first has initially cured. Its biggest disadvantage is that is not easy to maintain an even layer thickness over the whole piece with this method. In the case of large surfaces, coating time can also be problematic. To reduce manufacturing time, usually a special hand rolling method is applied, but not every gelcoat system in brush consistency is suitable for this rolling method; sometimes special systems are required [65]. According to Saltz, spray application is better than brushing or other hand lay-up techniques, because of its increased productivity, and lower volatile organic compound (VOC) emission [66]. Also, with spraying techniques, a larger variety of moulds (moulds with complicated geometry) can be used, while they require fewer man-hours [66]. Spraying compatible gelcoat systems have optimized viscosity and air release to meet the requirements of the method, but a lot of air brought into the gelcoat by spraying causes an increase in styrene emission in the case of styrene-based unsaturated polyester systems. During manufacturing, the spraying gun should be moved perpendicularly to the mould surface, and uncured gelcoat should be sprayed length-wise and cross-wise at a distance of approx. 0.5 m, depending on the materials used and the size of the spray nozzle [65]. Standard paint guns with a primer nozzle or preval sprayer are usually used. To minimize volatile organic compound (VOC) emission (especially styrene) and optimize air release, the sprayed droplets should be as large as possible, and spraying pressure should be low [65].
3.2. Novel Methods
In this section the most researched and promising novel gelcoating techniques are summarized. These novel techniques may eliminate the disadvantages of standard gelcoat processing methods.
3.2.1. UV Curable Gelcoat Systems
One of the most important steps during the gelcoating process is the curing of the gelcoat. During curing, thermoset resins change from a liquid of low molecular weight or oligomeric compounds to solids with fully developed three dimensional cross-linked networks. Cross-links are usually formed by chemical reactions initiated by curing agents, temperature, pressure or radiation. One of the most researched methods is the photoinitiated curing of coatings. Standard two-component polymer formulations often need almost 12 hours of curing time [18,67] and extra heating at 60–160 °C to facilitate the hardening process [68]. Furthermore, a post-curing process is necessary as well to reach a highly cross-linked structure [69]. Also, there could be difficulties with producing large monolith constructions and coating large surfaces that can be temperature sensitive or when heating is not even possible [70]. The market of ultraviolet (UV) curable polymers has been growing rapidly in the last decades [71] because of the increased productivity of the method and adjustable properties [72]. Its main advantages in comparison to other conventional curing methods are short curing times (usually a few minutes) [73] and low VOC emission [74]. Intensive irradiation is necessary for the initiation of photoacid generation and cationic polymerization [75]. Usually, diverse electromagnetic irradiation sources are applied for photopolymerization curing, therefore visible light, UV lamps, X-ray generators and accelerated electron beam guns are successfully used for photo-curing processes [76,77,78,79]. From the three different UV regions (UV-A: 400–315 nm; UV-B: 315–280 nm; and UV-C: 280–100 nm [80]), UV-B and UV-C are commonly used to induce photopolymerization [81]. Gaidukovs et al. investigated UV-light induced curing of branched epoxy novolac resin for coatings [82]. The cationic photopolymerization of the epoxy novolac resin coatings was initiated by photodecomposition of bis(4-dodecylphenyl) iodonium hexaflurorantimonate. Photoinitiator content and irradiation time were changed, while their effect on the main characteristics of the coating was investigated. Researchers found an optimal photoinitiator content of 1.5% and an irradiation time of 3 minutes. In the case of these manufacturing properties, the photocured coatings reached the same hardness as the thermally cured two-component epoxy novolac coatings, presumably due to the dense cross-linking polymer network structure which developed. They stated that UV irradiation times longer than 6 minutes result in the photodegradation of the epoxy novolac resin [82]. This photopolymerization technology of the epoxy novolac resin can be applied to produce protective coatings for diverse applications in power generation and maritime industries, where the thermal curing process is not feasible.
Jiang et al. improved the performance of UV-curable coating with carbon nanomaterials (CNTs) [83]. A novel UV-curable coating matrix was designed and prepared on a polycarbonate (PC) substrate. Further modification with a relatively small amount of modified carbon nanotubes (CNTs) and graphene oxide (GO) improved the thermal stability, surface hardness, adhesion, abrasive resistance, and chemical resistance of the urethane acrylate-based coatings, which can be potentially applied in the 3C (Computer, Communication, and Consumer Electronics) industry [83].
3.2.2. In-Mould Gelcoating Processes
Other, relatively new methods are in-mould coating (IMC) techniques, which provide an even gelcoat thickness and reduced VOC emission. According to the recommendation of the European Styrene Producers Associations [84], the occupational exposure limit of VOCs is 20 ppm for an 8 h average, which is difficult to fulfill if conventional open mould gelcoating methods are used. The most common IMC techniques are compression moulding, injection moulding, liquid composite moulding (LCM), and resin infusion under double flexible tooling (RIDFT). The most studied possibilities to create a space of the right thickness in the mould for the coating are listed below [85]:
- Opening the mould a bit to create space for the injection of the gelcoat
- Using a third mould tool as the counter-face to create space
- Using a removable spacer material to define the space for the gelcoat
- Coating the fabric to minimize penetration of the gelcoat into the reinforcement
- Using a separator layer to keep the gelcoat and laminate apart
Harper patented an in-mould surfacing (IMS) technique in which a silicone shim fills the space where gelcoat will be injected [86]. The shim stays in the mould as long as the laminate is moulded, then the shim is removed, the mould is reclosed and the injection phase of the gelcoat begins. The injected gelcoat fills the remaining space in the cavity, then the whole system is cured [86]. Several researchers, such as Gombos and Summerscales [87], Landowski [88], Salit [89], and Raghavendra [90] investigated IMC techniques. Gombos and Summerscales compared two different IMC methods with the conventional open mould gelcoating technique [91]. The authors studied a conventional hand-painted gelcoat, an innovative in-mould gelcoating procedure with a trilayer separator fabric (IMGC) and in-mould surfacing with a silicone shim (IMS). They investigated the surface quality with a Wave-Scan device, while the adhesion of the gelcoat was characterized by pull-off tests. Both new approaches resulted in significant reductions in styrene emission values, however in the case of IMS, styrene release during shim removal remained an issue. The conventional hand painted gelcoats had a complete surface with just minor imperfections, but so did IMGC and IMS gelcoats as well. Researchers found that the IMGC technology only provided poor pull-off strength due to the delamination within the separator layer. This problem can be solved by integrating a stronger separator layer, but such alternative material has not been found yet. According to the authors, these new processes might offer a comparable surface and adhesive pull-off properties to commercial coated composites [91].
3.3. Common Defects
Sometimes, various defects can occur during gelcoating, which may arise form insufficient moulding techniques, wrong parameter settings (such as temperature, humidity, or inadequate mixing ratios), but some defects can develop during application as well. Plessis gave an experimental investigation of various type of defects [92], but other researchers [93] and gelcoat distributors had dealt with this obviously important topic before [94,95], and provided useful advice to users about the defects, their cause and how to avoid the most common defects. A remarkable defect is the sagging of the gelcoat, which results in an uneven thickness and therefore an inadequate gelcoat performance on the surface. The common causes are improper spraying (including application of the wrong spray tip or too high spray pressure), high gelcoat thickness, flooding of the gelcoat because of its too low viscosity, slow curing or sometimes vibration of the mould before gelation. With the proper parameter and compound selection, this phenomenon can be avoided [94,95]. Wrinkles are often observable on the surface of the coating. These look like a centipede or dried apple skin and are typically caused by the resin, the lay-up process, a too-thin gelcoat layer, or styrene build-up in the case of unsaturated polyester gelcoats. Sometimes a second gelcoat is being applied earlier prior to the complete curing of the first layer, which has a softening effect on the layer, and leads to the formation of wrinkles. Alligatoring is a phenomenon similar to wrinkles and usually caused by insufficient curing, inadequate coating thickness, low mould and/or gelcoat temperature, too high or too low catalyst level or long gelation times [92,95]. Wrinkles and alligatoring can be prevented with proper technological parameters and accurate composition of the compounds. Sometimes, crazes and pin holes can be seen on the gelcoat surface, which are the results of trapped solvent, fat gelation times, low temperature or improper pressure in the case of spraying methods. Crazes can be filled with more gelcoat material or sometimes another gelcoating step is required before polishing the surface, although a second layer may result in excessive thickness, which leads to other problems (e.g., increased weight, sagging, or the detachment of gelcoat). These crazes can cause premature failure, because they can act like initiation points for cracks. As a treatment, more flexible gelcoat systems were developed, although in the case of these gelcoats, another defect occurs, which is blistering [92]. Blistering is generally caused by unreacted, undispersed or too much catalyst, undercured surface, contamination on the surface of the mould or the laminate, or entrapped solvent, water, or air [94,95]. In the case of clean equipment and proper component mixing, the entrapped air can be rolled out of the laminate [95]. Cracks usually come from the impact from the laminate side in the case of high gelcoat thickness, but incorrect demolding procedures or weak adhesion on the gelcoat-laminate interface may cause cracks as well. Proper selection of the laminate matrix resin and gelcoat material is necessary. Fisheyes are black spots on the thin gelcoat caused by remaining dust or dirt on the mould during gelcoat preparation. This defect can only be eliminated with a perfectly clean mould surface, but after its occurrence it can be repaired by painting the surface. Chalking can be caused by an inappropriate catalyst level, unreacted catalyst, poor cure or incorrect product selection, but insufficient buffing of the tool or poor mould condition is unfavorable as well, which can be avoided if the mould surface is prepared properly, including wiping with solvents (e.g. acetone) before the molding process [92,94,95]. Most of the defects can be traced back to the use of incorrect materials, improper processing conditions and contaminations, therefore a full overview is required before manufacturing. The most common gelcoat defects are summarized in Table 3.

Table 3.
Common gelcoat defects [92,95].
4. Testing Methods
Different gelcoat functions require different testing methods. Conventional resin analysis methods are commonly used to characterize the chemical structure and the thermal behavior of the gelcoat resin materials. These techniques can be chromatographic methods (Gas Chromatography (GC), High-Performance Liquid Chromatography (HPLC), Gel Permeation Chromatography (GPC), Supercritical Fluid Chromatography (SFC)), spectroscopic methods (Nuclear Magnetic Resonance Spectroscopy (NMR), Fourier Transform Infrared Spectroscopy (FTIR), Mass Spectrometry (MS), X-ray Fluorescence Spectroscopy etc.) [8]. Thermal properties are usually tested by Differential Scanning Calorimetry (DSC), Thermogravimetric Analysis (TGA) and Thermomechanical Analysis methods, such as Dynamic Mechanical Analysis (DMA) [8]. Beyond these and some other conventional methods (such as thickness measurement), mechanical tests and special measurements tied to gelcoat functionality (like corrosion resistance, flame retardancy etc.) play an important role. This section focuses on these testing methods.
4.1. Mechanical Testing Methods
Classical mechanical testing methods are commonly used to characterize the coated composites. However, gelcoats—because of their definition—do not modify the bulk properties of composites, still the characterization of gelcoats is important. Conventional mechanical tests, such as a standard tensile test, a 3-point bending test, a Charpy impact test or falling weight impact test can be done on samples made from the neat, cured gelcoat. The most important feature is adhesion between the gelcoat and the composite matrix. A discussion of the adhesion of surface coatings has been published by the Paint Research Association [96]. Potentially suitable standards for adhesion testing are listed below:
• BS EN ISO 2409 [97]/BS 3900-E6 [98]
A piece of tape with a defined adhesion strength is applied and pulled off the lattice pattern cut from the surface coating. A pictorial scale categorizes the pull-off. This method is fast, cost-effective, simple, and can be used on site. However, its maximum coating thickness limit is 250 µm, and it is not suitable for the majority of gelcoats which are typically >500 µm. The American Society for Testing and Materials (ASTM) equivalent standard is ASTM D-3359-02 [99] (Standard Test Methods for Measuring Adhesion by Tape Test).
• BS EN 24624 [100]/ISO 4624 [101]
It is a tensile pull-off test method, which has several variations and is suitable for rigid and flexible substrates with a paint finish on one (in the case of rigid substrates) or both sides (rigid and flexible substrates). Test “dollies” with 20 mm diameter cylinders are attached with a suitable adhesive to one or each side of the test specimen. After the curing of the adhesive, the interface is pulled with a gradually increasing force. With this method, accurate adhesion strength can be calculated because the exact cross-section of the specimen is known [91]. This method is perhaps the best suited to gelcoat applications [85,91]. ASTM D4541-95E1 [102] (Standard Test Method for Pull-Off Strength of Coatings Using Portable Adhesion Testers) is a comparable standard, but does not require a laboratory tensile tester [85].
• BS 5350: Part C14:1979 [103]
A climbing drum is applied to peel a flexible coating from the surface. It is not so practical in the case of brittle coating, and totally inadequate for the determination of the interface strength of gelcoats.
Among others, Gombos and Summerscales successfully applied the pull-off adhesion test (ISO 4624) to determine the adhesion strength between gelcoats and fiber reinforced composite substrates made by conventional hand painting, in-mould gelcoating (IMGC) and in-mould surfacing (IMS) [91].
4.2. Testing Methods for Multifunctional Gelcoats
As mentioned above, multifunctional coatings require special testing techniques. The number of functionalities is high, therefore the aim of this section is to mention some of the most important issues and their testing methods in an industrial environment.
One of the most relevant factors is weather resistance. Composite structures are often used outdoors, for example aircraft, sailing boats, and wind turbines. These composites have protective and multifunctional surface coatings in almost every case. Weather can cause damage to wind turbines during changes from frost to thaw, while sand and salt cause blistering of the surface of the blade, but water diffusion and chemical or ozone degradation can be harmful as well [104]. Wear will affect the adhesion between the surface coating and the laminate, which leads a decrease in the strength of the surface layer or sometimes a loss of function. However, these rotor blades cannot be protected completely; engineers can only aim to provide as much protection as possible. In case of multifunctional coatings, research and development is very important, therefore weather resistance testing and other tests are essential in this industry. It is also preferable to test the subject or specimen in its natural environment so as to test its behavior during operation. Of course, this method is sometimes difficult, time consuming or even impossible. One possible method to measure the surface degradation based on color change [105]. There are rapid color testers, which can help identify the degree of degradation. Under laboratory conditions, color change can be measured with spectroscopic methods [106].
UV and xenon light tests with different wavelengths are often used to predict the lifetime of surface protective coatings. UV tests usually use UV-A radiation, which is the most common type of UV radiation on Earth. Although UV-B radiation is detectable—especially where the protective ozone layer is thinner—it is not applied during measurements, because UV-B radiation causes rapid degradation. With xenon lights, a distribution of wavelengths can be simulated; it is more like the distribution of sunlight [104]. The Norsok Standard M-501 is one of the standards developed by the Norwegian petroleum industry [106]. The test normally takes place in an UV-A or a xenon light chamber at an elevated temperature over 32 weeks. After that, the surface of the specimen is examined according to the ISO 4628 standard for blistering, cracking, and flaking, and according to ISO 12944-2 [107] for adhesion [104].
The effect of ozone, humidity, and temperature are investigated in an ozone cabinet, where the specimens are usually examined over 72 h with an ozone concentration of 50 ppm [104]. Although it is possible to perform mechanical tests in the cabinet as well, the method has limited use in the case of large coated composite parts. However, there are combined weather tests, where the specimens can be exposed to multiple conditions and/or cyclical influences (for example, a UV-A test combined with oxygen tests, humidity tests, salt spray tests, ice and frost tests etc.). Sometimes, these combined tests give the best results, though they are time consuming and not cost-effective [104].
Flame retardant gelcoats are also widely used, especially in the aerospace and railway industry. Typical large-scale tests in the USA are the ASTM E-84 [108] standard test for flame spread and the ASTM E119 [109] standard test for fire resistance. The ASTM E1529 [110] standard predicts protection time in a rapid temperature rise fire, which may occur on offshore oil or gas platforms. This test requires a furnace, which develops an average temperature of 1093 °C in the first 5 min of the test [111]. The test methods mentioned above are all large-scale tests with special, dedicated equipment. ASTM E-84 is commonly used to measure the effectiveness of FR coating against flame spread for construction materials, such as wood, while ASTM E119 is suitable for the investigation of the fire performance of walls, doors and floors [111]. There are some small-scale screening tests as well, such as the one developed by Jimenez et al. [112]. A small radiant heater is used during the test, directed downward on a 50 × 50 mm2 plate painted with the tested FR coating. The bottom temperature of the plate is read by an infrared thermometer.
5. Summary
With the expansion of polymer composite application areas, the need for composites with special features, such as thermal and electrical conductivity, flame retardancy, long-term weather resistance, and corrosion resistance, increases rapidly. These properties are usually achieved with the application of different additives. A possible solution to reach these features without altering the bulk properties of the polymer matrix and to avoid various processing issues related to the use of additives, is to apply a separate layer on the surface of the polymer composite.
In many applications gelcoats are used to provide the required surface protection and aesthetic appearance, but with the incorporation of functional additives in the gelcoat, multifunctional gelcoats can be produced. Different industries have different special needs, such as water resistance in the marine industry, electric conductivity (lightning strike protection) in the aerospace industry and flame retardancy in the aerospace, automotive, railway, and construction industries. Multifunctional coatings became more and more convenient, economical and efficient way to protect surfaces against environmental effects, or fire. For example, FR coatings can provide excellent flame retardancy, while at the same time preserving the bulk properties of the material (e.g., mechanical properties). Another useful functionality of gelcoats could be the self-healing feature in the future (e.g., by incorporating phenol formaldehyde or urea formaldehyde resin based microcapsules [113] in the gelcoat).
Classical gelcoat preparation methods are well known and widely used by the composite industry, while novel techniques (e.g., photoinitiated curing of coatings, in-mould gelcoating techniques) are under continuous research with the aim of reaching shorter curing times, even gelcoat thickness and low VOC emission. Although, various defects can occur during gelcoating, which mostly arise from insufficient moulding techniques, wrong parameter settings (e.g. temperature, humidity, too long or too short curing times, or insufficient mixing ratios) or application, the producers and distributors supply the users with useful advice about the possible defects, their reason and ways to avoid them. Like in every industrial application, quality is one of the most important issues, which can be granted and confirmed by sufficient tests. Beyond the conventional testing methods (analytical tests, thickness measurement etc.), mechanical tests (such as standard pull-off adhesion test), special gelcoat functionalities require special testing methods (like corrosion resistance, weather resistance, and flame retardancy).
In this review, we summarized the main gelcoat base materials, the possibilities and importance of multifunctional coatings and gelcoats, their classical and novel preparation techniques, as well as some commonly used test methods. The use of these multifunctional coatings and gelcoats offers a possible solution to fulfill the extensive requirements related to the rapid expansion of polymer composite application fields.
Funding
This work was funded by the New National Excellence Program ÚNKP-18-3-I of the Ministry of Human Resources and by the Hungarian Scientific Research Fund (OTKA K120592). A. Toldy acknowledges the financial support received through the János Bolyai Scholarship of the Hungarian Academy of Sciences. This work was supported by the Higher Education Excellence Program of the Ministry of Human Capacities in the framework of the Nanotechnology research area of the Budapest University of Technology and Economics (BME FIKP-NANO).
Conflicts of Interest
The authors declare no conflict of interest.
References
- Laurenzi, S.; Marchetti, M. Advanced composite materials by resin transfer molding for aerospace applications. In Composites and Their Properties; Hu, N., Ed.; IntechOpen: London, UK, 2012; pp. 197–226. [Google Scholar]
- Groessing, H.; Becker, D.; Kaufmann, S.; Schledjewski, R.; Mitschang, P. An evaluation of the reproducibility of capacitive sensor based in-plane permeability measurements: A benchmarking study. Exp. Polym. Lett. 2015, 9, 129–142. [Google Scholar] [CrossRef]
- Pomázi, Á.; Toldy, A. Particle distribution of solid flame retardants in infusion moulded composites. Polymers 2017, 9, 250. [Google Scholar] [CrossRef]
- Toldy, A.; Szolnoki, B.; Marosi, G. Flame retardancy of fibre-reinforced epoxy resin composites for aerospace applications. Polym. Degrad. Stab. 2011, 96, 371–376. [Google Scholar] [CrossRef]
- Borsting, D.A.; Zhou, Q.; Van Der Zee, J.J.; Rajamani, R. Method of Applying Gelcoat and An Arrangement Performing Said Method. U.S. Patent 8,808,794 B2, 19 August 2014. [Google Scholar]
- Gascons, T.M. Assesment of Virtual Design and Manufacturing Techniques for Fibre Reinforced Composite Materials. Ph.D. Thesis, Universitat de Girona, Girona, Spain, February 2011. [Google Scholar]
- Fink, J.K. Reactive Polymers Fundamentals and Applications: A Concise Guide to Industrial Polymers; William Andrew Inc.: Norwich, NY, USA, 2006; ISBN 9780815515159. [Google Scholar]
- Stoye, D.; Werner, F. Resins for Coatings: Chemistry, Properties and Applications; Carl Hanser Verlag: Cincinnati, OH, USA, 1996; ISBN 3-446-18489-9. [Google Scholar]
- Airola, K.; Farm, O.; Mahbub, P.; Valtonen, E. Unsaturated Polyester Resin Compositions. U.S. Patent 6,617,417, 9 September 2003. [Google Scholar]
- Jones, F.R. Unsaturated polyester resins. In Brydson’s Plastics Materials, 8th ed.; Gilbert, M., Ed.; Butterworth-Heinemann: Oxford, UK, 2017; pp. 743–772. [Google Scholar]
- Li, L.; Sun, X.; Lee, L.J. Low temperature cure of vinyl ester resins. Polym. Eng. Sci. 1999, 39, 646–661. [Google Scholar] [CrossRef]
- Li, L.; Lee, L.J. Effects of inhibitors and retarders on low temperature free radical crosslinking polymerization between styrene and vinyl ester resin. Polym. Eng. Sci. 2001, 41, 53–65. [Google Scholar] [CrossRef]
- Roskott, L.; Groenendaal, A.A.M. Residual styrene content—What does this mean to the polyester processor. In Proceedings of the 33rd Annual Conference of Reinforced Plastics/Composites Institute, The Society of Plastics Industry, Section 5B, Washington, DC, USA, 7–10 February 1978. [Google Scholar]
- Li, L.; Lee, L.J. Effect of a chelating agent-2,4-pentanedione on low temperature composite molding of vinyl ester and unsaturated polyester resins. Polym. Compos. 2002, 23, 971–990. [Google Scholar] [CrossRef]
- Xu, L.; Lee, L.J. Effect of nanoclay on shrinkage control of low profile unsaturated polyester (UP) resin cured at room temperature. Polymer 2004, 45, 7325–7334. [Google Scholar] [CrossRef]
- Fan, J.D.; Lee, L.J. Optimization of polyester sheet molding compound. Part II: Theoretical modelling. Polym. Compos. 1986, 7, 250–260. [Google Scholar] [CrossRef]
- Li, L.; Cao, X.; Lee, L.J. Effect of dual-initiator on low temperature curing of unsaturated polyester resins. Polymer 2004, 45, 6601–6612. [Google Scholar] [CrossRef]
- Ellis, B. Chemistry and Technology of Epoxy Resins, 1st ed.; Springer Science: Dordrecht, The Netherlands, 1993; ISBN 978-94-010-5302-0. [Google Scholar]
- Clayton, A.; May, I. Epoxy Resins, 2nd ed.; Marcel Dekker Inc.: New York, NY, USA, 1988; ISBN 0-8247-7690-9. [Google Scholar]
- Konieczna, A.; Rutkowska, A.; Rachon, D. Health risk of exposure to Bisphenol A (BPA). Rocz. Panstw. Zakl. Hig. 2015, 66, 5–11. [Google Scholar] [PubMed]
- Kittel, H. Bindemittel für wasserverdünnbare Systeme. Lehrbuch der Lacke und Beschichtungen; Colomb: Berlin, Germany, 1976; Volume 3, p. 237. [Google Scholar]
- Scholz, W.; Kortmann, W. Paint additives. In Paints, Coatings and Solvents, 2nd ed.; Stoye, D., Freitag, W., Eds.; Wiley-VCH: Weinheim, Germany, 1998; pp. 159–173. ISBN 3-527-28863-5. [Google Scholar]
- Sudha, G.S.; Arun, K.V. Effect of gel coat on moisture absorption and mechanical behavior of jute-epoxy laminated composites. J. Eng. Res. Appl. 2018, 52–59. [Google Scholar]
- Firdosh, S.; Murthy, H.N.N.; Angadi, G.; Raghavendra, N. Investigation of water absorption characteristics of nano-gelcoat for marine application. Prog. Org. Coat. 2018, 114, 173–187. [Google Scholar] [CrossRef]
- Yardimci, A.I.; Tanoglu, M.; Selamet, Y. Development of electrically conductive and anisotropic gel-coat systems using CNTs. Prog. Org. Coat. 2013, 76, 963–965. [Google Scholar] [CrossRef]
- Powder Gelcoat Has Electrical Conductivity. Available online: https://www.materialstoday.com/composite-processing/products/powder-gelcoat-has-electrical-conductivity-/ (accessed on 2 March 2019).
- Surfacing Films Improve Safety, Appearance and Processing Time. Available online: https://www.compositesworld.com/articles/surfacing-films-improve-safety-appearance-and-processing-time (accessed on 2 March 2019).
- Jain, P.; Choudhary, V.; Varma, I.K. Flame retarding epoxies with phosphorous. J. Macromol. Sci. Part C Polym. Rev. 2002, 42, 139–183. [Google Scholar] [CrossRef]
- Levchik, S.V.; Weil, E.D. Thermal decomposition, combustion and flame-retardancy of epoxy resins—A review of the recent literature. Polym. Int. 2004, 53, 1901–1929. [Google Scholar] [CrossRef]
- Rakotomalala, M.; Wagner, S.; Döring, M. Recent developments in halogen free flame retardants for epoxy resins for electrical and electronic applications. Materials 2010, 3, 4300–4327. [Google Scholar] [CrossRef] [PubMed]
- Weil, E.D.; Levchik, S.V. Phosphorus flame retardants. In Krik-Othmer Encyclopedia of Chemical Technology; Kirk, R.E., Othmer, D., Eds.; John Wiley & Sons, Inc.: Hoboken, NJ, USA.
- Wang, J.; Su, X.; Mao, Z. The flame retardancy and thermal property of poly(ethylene terephthalate)/cyclotriphosphazene modified montmorillonite system. Polym. Degrad. Stab. 2014, 109, 154–161. [Google Scholar] [CrossRef]
- Zhang, R.C.; Hong, S.M.; Koo, C.M. Flame retardancy and mechanical properties of polyamide 6 with melamine polyphosphate and ionic liquid surfactant-treated montmorillonite. J. Appl. Polym. Sci. 2014, 131, 40648. [Google Scholar] [CrossRef]
- Ramani, A.; Dahoe, A.E. On flame retardancy in polycaprolactam composites by aluminim diethylphosphinate and melamine polyphosphate in conjunction with organically modified montmorillonite nanoclay. Polym. Degrad. Stab. 2014, 105, 1–11. [Google Scholar] [CrossRef]
- Yu, T.; Jiang, N.; Li, Y. Functionalized multi-wall carbon nanotube for improving the flame retardancy of ramie/poly(lactic acid) composite. Compos. Sci. Technol. 2014, 104, 26–33. [Google Scholar] [CrossRef]
- Pandey, P.; Mohanty, S.; Nayak, S.K. Improved flame retardancy and thermal stability of polymer/clay nanocomposites, with the incorporation of multiwalled carbon nanotube as secondary filler: Evaluation of hybrid effect of nanofillers. High Perform. Polym. 2014, 26, 826–836. [Google Scholar] [CrossRef]
- Zhang, Z.; Yuan, L.; Liang, G.; Gu, A.; Qiang, Z.; Chen, X. Unique hybridized carbon nanotubes and their high performance flame retarding composites with high smoke suppression, good toughness and low curing temperature. J. Mater. Chem. 2014, 2, 4975–4988. [Google Scholar] [CrossRef]
- Yu, B.; Shi, Y.; Yuan, B.; Qiu, S.; Xing, W.; Hu, W.; Song, L.; Lo, S.M.; Hu, Y. Enhanced thermal and flame retardant properties of flame-retardant-wrapped graphene/epoxy resin nanocomposites. J. Mater. Chem. 2015, 3, 8034–8044. [Google Scholar] [CrossRef]
- Dittrich, B.; Wartig, K.A.; Mülhaup, R.; Shartel, B. Flame-retardancy properties of intumescent ammonium poly(phosphate) and mineral filler magnesium hydroxide in combination with graphene. Polymer 2014, 6, 2875–2895. [Google Scholar] [CrossRef]
- Ran, S.; Chen, C.; Guo, Z.; Fang, Z. Char barrier effect of graphene nanoplatelets on the flame retardancy and thermal stability of high-density polyethylene flame-retarded by brominated polystyrene. J. Appl. Sci. 2014, 131, 40520. [Google Scholar] [CrossRef]
- Han, Y.; Wu, Y.; Shen, M.; Huang, X.; Zhu, J.; Zhang, X. Preparation and properties of polystyrene nanocomposites with graphite oxide and graphene as flame retardants. J. Mater. Sci. 2013, 48, 4214–4222. [Google Scholar] [CrossRef]
- Lu, S.-Y.; Hammerton, I. Recent developments in the chemistry of halogen-free flame retardant polymers. Prog. Polym. Sci. 2002, 27, 1661–1712. [Google Scholar] [CrossRef]
- Huang, H.; Tian, M.; Liu, I.; Liang, W.; Zhang, I. Effect of particle size on flame retardancy of Mg(OH)2-filled ethylene vinyl acetate copolymer composites. J. Appl. Polym. Sci. 2006, 100, 4461–4469. [Google Scholar] [CrossRef]
- Du, L.; Xu, G.; Zhang, Y.; Qian, J.; Chen, J. Synthesis and properties of a novel intumescent flame retardant (IFR) and its application in halogen-free flame retardant ethylene propylene diene terpolymer (EPDM). Polym.-Plast. Technol. Eng. 2011, 50, 372–378. [Google Scholar] [CrossRef]
- Laoutid, F.; Bonnaud, L.; Alexandre, M.; Lopez-Cuesta, J.M.; Dubois, P. New prospects in flame retardant polymer materials: From fundamentals to nanocomposites. Mater. Sci. Eng. R Rep. 2009, 63, 100–125. [Google Scholar] [CrossRef]
- Fire Safety with Specialty Coatings. Available online: http://www.tpr2.com/news/JCT-fire-suppressant-coatings.pdf (accessed on 5 March 2019).
- Qu, H.; Wu, W.; Zheng, Y.; Xie, J.; Xu, J. Synergistic effects of inorganic tin compounds and Sb2O3 on thermal properties and flame retardancy of flexible poly(vinyl chloride). Fire Saf. J. 2011, 46, 462–467. [Google Scholar] [CrossRef]
- Chattopadhyay, D.K.; Raju, K.V.S.N. Structural engineering of polyurethane coatings for high performance applications. Prog. Polym. Sci. 2007, 32, 352–418. [Google Scholar] [CrossRef]
- Mouritz, A.P.; Gibson, A.G. Fire Properties of Polymer Composite Materials; Springer: Dordrecht, The Netherlands, 2006; pp. 236–284. ISBN 1-4020-5355-X. [Google Scholar]
- Knop, S.; Krieger, W. Flame retardant gelcoats on composite laminates. In Proceedings of the Composites in Fire, Newcastle upon Tyne, UK, 9–10 September 2003; pp. 29–34. [Google Scholar]
- Gelcoats, UP and Urethane Acrylic Resins, Fibers. Available online: https://www.madercomposites.com/ENG/Produkte.html (accessed on 30 January 2019).
- CCP Composites. Available online: http://www.feiplar.com.br/coberturas/2014/materiais/palestras/automotivo/CCP.pdf (accessed on 30 January 2019).
- New Technology Fire Retardant Gelcoats and Topcoats Protecting Composites from Fire. Available online: http://jp.scottbader.com/uploads/files/5496_crystic-fireguard-range-english.pdf (accessed on 30 January 2019).
- SGi 128/SD 228 Fire Resistant Epoxy Gel Coat. Available online: http://www.sicomin.com/datasheets/product-pdf1237.pdf (accessed on 30 January 2019).
- Fire Retardant (FR) Resins. Available online: https://www.ashland.com/file_source/Ashland/Product/Documents/Composites/Fire%20Retardant%20Linecard%20(2).pdf (accessed on 30 January 2019).
- Enguard™ FR Series Gelcoats Chemistry: Composites. Available online: https://www.ashland.com/industries/building-and-construction/fire-retardant-materials/enguard-fr-series-gelcoats (accessed on 30 January 2019).
- Fireblock. Available online: http://www.polynt.com/en/chemical-products/composites/gelcoats/fireblock/?product-name=FIREBLOCK%202330PAWK745 (accessed on 15 February 2019).
- Toldy, A. Flame retardancy of carbon fibre reinforced composites. Exp. Polym. Lett. 2018, 12, 186. [Google Scholar] [CrossRef]
- Luangtriratana, P. Thermal Insulation of Polymeric Composites Using Surface Treatments. Ph.D. Thesis, University of Bolton, Bolton, UK, January 2014. [Google Scholar]
- Price, D.; Pyrah, K.; Hull, T.R.; Milnes, G.J.; Ebdon, J.R.; Hunt, B.J.; Joseph, P.; Konkel, C.S. Flame retarding poly(methyl methacrylate) with phosphorous containing compounds: Comparison of an additive with a reactive approach. Polym. Degrad. Stab. 2001, 74, 441–447. [Google Scholar] [CrossRef]
- Kahraman, M.V.; Apohan, N.K.; Arsu, N.; Güngör, A. Flame retardance of epoxy acrylate resin modified with phosphorus containing compounds. Prog. Org. Coat. 2004, 51, 213–219. [Google Scholar] [CrossRef]
- Akmakc, E.C.; Mülazim, Y.; Kahraman, M.V.; Apohan, N.K. Flame retardant thiolene photocured coatings. React. Funct. Polym. 2011, 71, 36–41. [Google Scholar] [CrossRef]
- Imamoglu, T.; Yaggi, Y. Photocuring of acrylate oligomers in the presence of vinyl phosphonic acids as a flame retarding monomer and the properties of the cured films. Turk. J. Chem. 2001, 25, 1–9. [Google Scholar]
- Huang, Z.; Shi, W. Synthesis and properties of a novel hyperbranched polyphosphate acrylate applied to UV curable flame retardant coatings. Eur. Polym. J. 2007, 43, 1302–1312. [Google Scholar] [CrossRef]
- Yuharzi, M.Y.; Haeryip, S.; Muhammad Zaimi, Z.A.; Nilson, G.C.H. A review on gelcoat used in laminated composite structure. Int. J. Res. Eng. Technol. 2015, 4, 49–58. [Google Scholar] [CrossRef]
- Saltz, W.T. Bay Area 2005 Ozone Strategy. Control Measure SS-4B, BAAQMD Regulation 8, Rule 50: Polyester Resin Operations. Available online: http://www.baaqmd.gov/~/media/files/planning-and-research/rules-and-regs/workshops/0850_wsrpt_080309.pdf (accessed on 30 January 2019).
- Ratna, D. Handbook of Thermoset Resins; Smithers Rapra Technology: Akron, OH, USA, 2009; ISBN 1847354105. [Google Scholar]
- Burton, B.L. Amine curing of epoxy resins: Options and key formulation considerations. Paint Coat. Ind. 2006, 22, 68–77. [Google Scholar]
- Ren, S.-P.; Lan, Y.-X.; Zhen, Y.-Q.; Ling, Y.-D.; Lu, M.-G. Curing reaction characteristics and phase behaviors of biphenol type epoxy resins with phenol Novolac resins. Thermochim. Acta 2006, 440, 60–67. [Google Scholar] [CrossRef]
- Dodiuk, H.; Goodman, S. Handbook of Thermoset Plastics, 3rd ed.; William Andrew: Amsterdam, The Netherlands, 2013; ISBN 9781455731077. [Google Scholar]
- Cohen, G. UV/EB Market Trends. Available online: https://www.radtech.org/images/pdf_upload/UV-EBMarketTrends7.12.pdf (accessed on 5 March 2019).
- Mark, H.F. Encyclopedia of Polymer Science and Technology, 4th ed.; Wiley: London, UK, 2003; ISBN 978-1-118-63389-2. [Google Scholar]
- Boey, F.; Rath, S.K.; Ng, A.K.; Abadie, M.J.M. Cationic UV cure kinetics for multifunctional epoxies. J. Appl. Polym. Sci. 2002, 86, 518–525. [Google Scholar] [CrossRef]
- Davidson, R.S.; Holman, R.J. Developments and trends in radiation curing. Color. Technol. 2003, 33, 46–58. [Google Scholar] [CrossRef]
- Sangermano, M.; Razza, N.; Crivello, J.V. Cationic UV-curing: Technology and applications. Macromol. Mater. Eng. 2014, 299, 775–793. [Google Scholar] [CrossRef]
- Decker, C. UV radiation curing chemistry. Pigment Resin Technol. 2001, 30, 278–286. [Google Scholar] [CrossRef]
- Crivello, J.V. UV and electron beam.induced cationic polymerization. Nucl. Instrum. Methods Phys. Res. Sect. B Beam Interact. Mater. Atoms 1999, 151, 8–21. [Google Scholar] [CrossRef]
- Li, F.; Bao, J.; Chen, X.; Bao, H.; Wang, H. Factors influencing EB curing of epoxy matrix. Radiat. Phys. Chem. 2002, 63, 557–561. [Google Scholar] [CrossRef]
- Shi, S.; Croutxé-Barghorn, C.; Allonas, X. Photoinitiating systems for cationic photopolymerization: ongoing push toward long wavelengths and low light intensities. Prog. Polym. Sci. 2017, 65, 1–41. [Google Scholar] [CrossRef]
- ISO 21348 Definitions of Solar Irradiance Spectral Categories; ISO: Geneva, Switzerland, 2017.
- Liaw, I.I.; Boyd, I.W. The development and application of UV excimer lamps in nanofabrication. In NATO Science for Peace and Security Series B: Physics and Biophysics; Vaseashta, A., Mihailescu, I.N., Eds.; Springer: Dordrecht, The Netherlands, 2008; pp. 61–76. [Google Scholar] [CrossRef]
- Gaidukovs, S.; Medvids, A.; Onufrijevs, P.; Grase, L. UV-light-induced curing of branched epoxy novolac resin for coatings. Exp. Polym. Lett. 2018, 12, 918–929. [Google Scholar] [CrossRef]
- Jiang, Y.; Zhang, S.Y.; Zhang, X.L.; Zhang, T. Improving the performance of UV-curable coatings with carbon nanomaterials. Exp. Polym. Lett. 2018, 12, 628–639. [Google Scholar] [CrossRef]
- Occupational Exposure to Styrene. Available online: http://www.upresins.org/wp-content/uploads/2017/09/170731_UPR_SHG2_EN.pdf (accessed on 5 March 2019).
- Rogers, W.; Hoppins, C.; Gombos, Z.J.; Summerscales, J. In-mould gel-coating of polymer composites: a review. J. Clean. Prod. 2014, 70, 282–291. [Google Scholar] [CrossRef]
- Harper, A.R. Production of Composite Mouldings. Patent WO2013132211, 2 September 2013. [Google Scholar]
- Gombos, Z.J.; Summerscales, J. In-mould Gel-Coating with A Separator Layer. Available online: https://slideplayer.com/slide/7252982/ (accessed on 5 March 2019).
- Landowski, M.; Budzik, M.; Imielinska, K. Water absorption and blistering of glass fibre-reinforced polymer marine laminates with nanoparticle modified coating. J. Comp. Mater. 2014, 48, 2805–2813. [Google Scholar] [CrossRef]
- Salit, M.S. Manufacturing techniques of tropical natural fibre composites. In Tropical Natural Fibre Composites; Springer: Singapore, 2014; pp. 103–118. [Google Scholar]
- Raghavendra, N.; Murthy, H.N.N.; Krishna, M.; Mahesh, K.R.V.; Sridhar, R.; Firdosh, S.; Angadi, G.; Sharma, S.C. Mechanical behavior of organo-modified Indian bentonite nanoclay fibre-reinforced plastic nanocomposites. Fron. Mater. Sci. 2013, 7, 396–404. [Google Scholar] [CrossRef]
- Gombos, Z.J.; Summerscales, J. In-mould gel-coating for polymer composites. Compos. Part A 2016, 91, 203–210. [Google Scholar] [CrossRef]
- Plessis, H.D. Fiberglass Boats: Construction, Gel Coat, Stressing, Blistering, Repair, Maintenance, 5th ed.; Adlard Coles Nautical: London, UK, 2010; pp. 160–162. ISBN 978-1-4081-2274-7. [Google Scholar]
- Lubin, G.E. Handbook of Composites, 1st ed.; Van Nostrand Reinhold Company Inc.: New York, NY, USA, 1982; ISBN 978-1-4615-7141-4. [Google Scholar]
- Ashland Gelcoat Felhasználási Útmutató. Available online: http://www.novia.hu/downloads/download.php?file=../admin_upload/felh_tanacsok_item_docs/18_Gelcoatguide201009HUN.pdf (accessed on 30 January 2019).
- Gelcoat Application Guide. Available online: https://www.ashland.com/file_source/Ashland/links/Gelcoat%20Application%20Guide.pdf (accessed on 30 January 2019).
- Mechanical Properties. Available online: http://www.pra-world.com/technical_services/laboratory/testing/mechanical#iso4624 (accessed on 8 October 2013).
- BS EN ISO 2409:2013 Paints and Varnishes. Cross-Cut Test; International Organization for Standardization: Geneva, Switzerland, 2013.
- BS 3900-E6 Paint and Varnishes. Cross-Cut Test; British Standard Institution: London, UK, 1974.
- ASTM D3359-02 Standard Test Methods for Measuring Adhesion by Tape Test; ASTM International: West Conshohocken, PA, USA, 2002.
- BS EN 24624:1993 Paints and Varnishes. Pull-off Test; British Standard Institution: London, UK, 1993.
- EN ISO 4624:2002 Paints and Varnishes—Pull-Off Test for Adhesion; International Organization for Standardization: Geneva, Switzerland, 2002.
- ASTM D4541-95E1 Standard Test Method for Pull-Off Strength of Coatings Using Portable Adhesion Testers; ASTM International: West Conshohocken, PA, USA, 2002.
- BS 5350: Part C14:1979 Methods of Test for Adhesives. Adhesively Bonded Joints: Mechanical Tests. 90° Peel Test for A Rigid-to-Rigid Assembly; British Standard Institution: London, UK, 1979.
- Storm, B.K. Surface protection and coatings for wind turbine rotor blades. In Advances in Wind Turbine Blade Design and Materials; Brøndsted, P., Nijssen, R., Eds.; Woodhead Publishing Ltd.: Cambridge, UK, 2013; pp. 387–412. [Google Scholar] [CrossRef]
- DS/EN ISO 2813 Paints and Varnishes—Determination of Specular Gloss of Non-Metallic Paint Films at 20 °C, 60 °C and 85 °C; International Organization for Standardization: Geneva, Switzerland, 2000.
- Norsok Standard M-501: Surface Preparation and Protective Coating; Norwegian Petroleum Industry: Lysaker, Norway, 2004.
- ISO 12944-2:2017 Paints and Varnishes–Corrosion Protection of Steel Structures by Protective Paint Systems–Part 2: Classification of Environments; International Organization for Standardization: Geneva, Switzerland, 2017.
- ASTM E-84-18b Standard Test Method for Surface Burning Characteristics of Building Materials; ASTM International: West Conshohocken, PA, USA, 2018.
- ASTM E119-18ce01 Standard Test Methods for Fire Tests of Building Construction and Materials; ASTM International: West Conshohocken, PA, USA, 2018.
- ASTM E1529-16e1 Standard Test Methods for Determining Effects of Large Hydrocarbon Pool Fires on Structural Members and Assemblies; ASTM International: Conshohocken, PA, USA, 2016.
- Weil, E.D. Fire-protective and flame-retardant coatings—A State-of-the-Art Review. J. Fire Sci. 2011, 29, 259–296. [Google Scholar] [CrossRef]
- Jimenez, M.; Duquesne, S.; Bourbigot, S. High-throughput fire testing for intumescent coatings. Ind. Eng. Chem. Res. 2006, 45, 7475–7481. [Google Scholar] [CrossRef]
- Ataei, S.; Khorasani, S.N.; Neisiany, R.E. Biofriendly vegetable oil healing agents used for developing self-healing coatings: A review. Prog. Org. Coat. 2019, 129, 77–95. [Google Scholar] [CrossRef]
© 2019 by the authors. Licensee MDPI, Basel, Switzerland. This article is an open access article distributed under the terms and conditions of the Creative Commons Attribution (CC BY) license (http://creativecommons.org/licenses/by/4.0/).